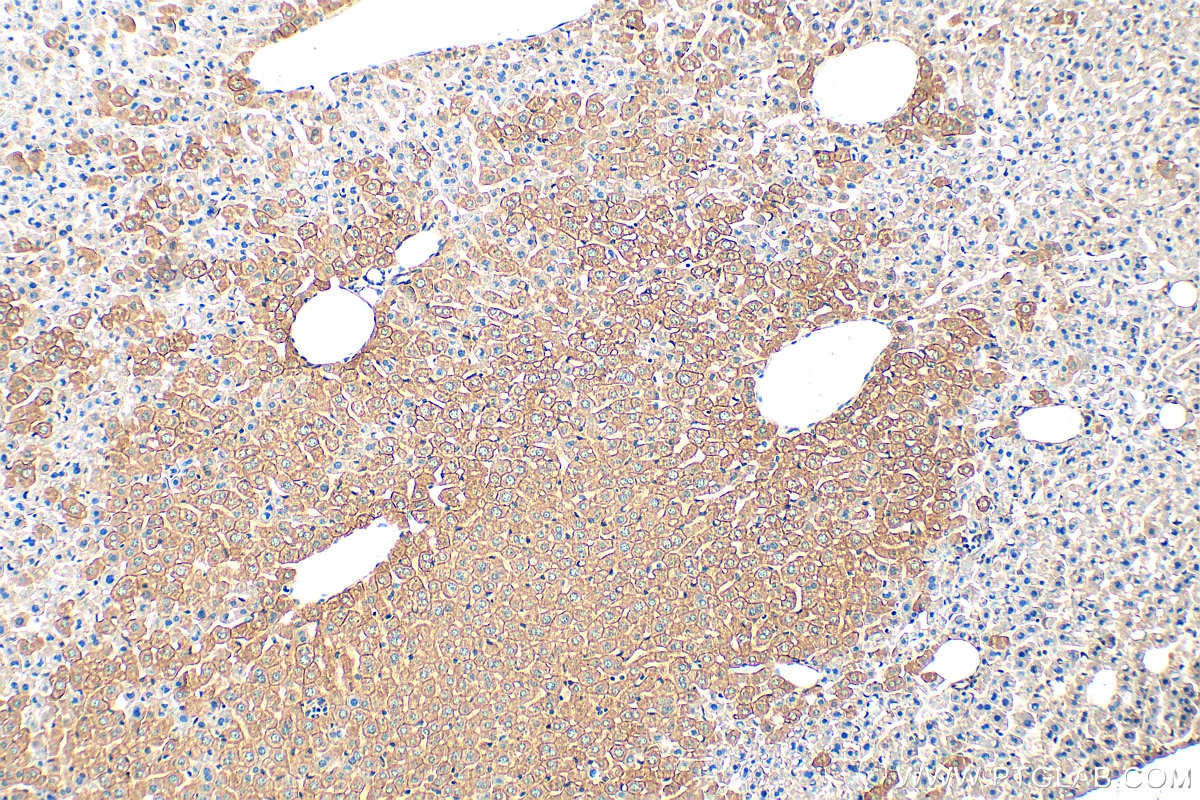
Immunohistochemistry (IHC) staining of mouse liver tissue using Cytokeratin 18 Polyclonal antibody (10830-1-AP)

Validation Data Gallery
Tested Applications
| Positive WB detected in | A431 cells, HeLa cells, K-562 cells, MCF-7 cells, MDA-MB-231 cells, mouse liver tissue, rat liver tissue |
| Positive IP detected in | A431 cells |
| Positive IHC detected in | human liver tissue, human appendicitis tissue, human breast cancer tissue, human colon cancer tissue, human endometrial cancer tissue, human kidney tissue, human liver cancer tissue, human lung cancer tissue, human ovary tumor tissue, human pancreas cancer tissue, human prostate hyperplasia tissue, human renal cell carcinoma tissue, human stomach cancer tissue, human tonsillitis tissue, mouse liver tissue, rat liver tissue Note: suggested antigen retrieval with TE buffer pH 9.0; (*) Alternatively, antigen retrieval may be performed with citrate buffer pH 6.0 |
| Positive IF/ICC detected in | HepG2 cells, HeLa cells |
| Positive FC (Intra) detected in | HeLa cells |
Recommended dilution
| Application | Dilution |
|---|---|
| Western Blot (WB) | WB : 1:20000-1:100000 |
| Immunoprecipitation (IP) | IP : 0.5-4.0 ug for 1.0-3.0 mg of total protein lysate |
| Immunohistochemistry (IHC) | IHC : 1:500-1:2000 |
| Immunofluorescence (IF)/ICC | IF/ICC : 1:200-1:800 |
| Flow Cytometry (FC) (INTRA) | FC (INTRA) : 0.80 ug per 10^6 cells in a 100 µl suspension |
| It is recommended that this reagent should be titrated in each testing system to obtain optimal results. | |
| Sample-dependent, Check data in validation data gallery. | |
Published Applications
| WB | See 40 publications below |
| IHC | See 29 publications below |
| IF | See 64 publications below |
Product Information
10830-1-AP targets Cytokeratin 18 in WB, IHC, IF/ICC, FC (Intra), IP, ELISA applications and shows reactivity with human, mouse, rat samples.
| Tested Reactivity | human, mouse, rat |
| Cited Reactivity | human, mouse, rat, pig, monkey, bovine, sheep, goat, duck |
| Host / Isotype | Rabbit / IgG |
| Class | Polyclonal |
| Type | Antibody |
| Immunogen |
CatNo: Ag1260 Product name: Recombinant human KRT18 protein Source: e coli.-derived, PGEX-4T Tag: GST Domain: 127-430 aa of BC000180 Sequence: SHYFKIIEDLRAQIFANTVDNARIVLQIDNARLAADDFRVKYETELAMRQSVENDIHGLRKVIDDTNITRLQLETEIEALKEELLFMKKNHEEEVKGLQAQIASSGLTVEVDAPKSQDLAKIMADIRAQYDELARKNREELDKYWSQQIEESTTVVTTQSAEVGAAETTLTELRRTVQSLEIDLDSMRNLKASLENSLREVEARYALQMEQLNGILLHLESELAQTRAEGQRQAQEYEALLNIKVKLEAEIATYRRLLEDGEDFNLGDALDSSNSMQTIQKTTTRRIVDGKVVSETNDTKVLRH 相同性解析による交差性が予測される生物種 |
| Full Name | keratin 18 |
| Calculated molecular weight | 48 kDa |
| Observed molecular weight | 48 kDa |
| GenBank accession number | BC000180 |
| Gene Symbol | Cytokeratin 18 |
| Gene ID (NCBI) | 3875 |
| RRID | AB_2133164 |
| Conjugate | Unconjugated |
| Form | |
| Form | Liquid |
| Purification Method | Antigen affinity purification |
| UNIPROT ID | P05783 |
| Storage Buffer | PBS with 0.02% sodium azide and 50% glycerol{{ptg:BufferTemp}}7.3 |
| Storage Conditions | Store at -20°C. Stable for one year after shipment. Aliquoting is unnecessary for -20oC storage. |
Background Information
Keratins are a large family of proteins that form the intermediate filament cytoskeleton of epithelial cells, which are classified into two major sequence types. Type I keratins are a group of acidic intermediate filament proteins, including K9-K23, and the hair keratins Ha1-Ha8. Type II keratins are the basic or neutral courterparts to the acidic type I keratins, including K1-K8, and the hair keratins, Hb1-Hb6. KRT18, also named as CYK18, PIG46 and K18, is the most commonly found members of the intermediate filament gene family. KRT18 is a type I keratin which is found primarily in non squamous epithelia and is present in a majority of adenocarcinomas and ductal carcinomas but not in squamous cell carcinomas.
Protocols
| Product Specific Protocols | |
|---|---|
| FC protocol for Cytokeratin 18 antibody 10830-1-AP | Download protocol |
| IF protocol for Cytokeratin 18 antibody 10830-1-AP | Download protocol |
| IHC protocol for Cytokeratin 18 antibody 10830-1-AP | Download protocol |
| IP protocol for Cytokeratin 18 antibody 10830-1-AP | Download protocol |
| WB protocol for Cytokeratin 18 antibody 10830-1-AP | Download protocol |
| Standard Protocols | |
|---|---|
| Click here to view our Standard Protocols |
Publications
| Species | Application | Title |
|---|---|---|
Cell Stem Cell Injury Induces Endogenous Reprogramming and Dedifferentiation of Neuronal Progenitors to Multipotency. | ||
Hepatology Fat-associated Lymphoid Clusters as Expandable Niches for Ectopic Liver Development. | ||
J Control Release Mesenchymal stem cell exosomes as nanotherapeutics for dry age-related macular degeneration | ||
Acta Biomater A KPV-binding double-network hydrogel restores gut mucosal barrier in an inflamed colon. | ||
Proc Natl Acad Sci U S A Basal epithelial stem cells are efficient targets for prostate cancer initiation. | ||
Proc Natl Acad Sci U S A Role of estrogen receptor beta in uterine stroma and epithelium: Insights from estrogen receptor beta-/- mice. |